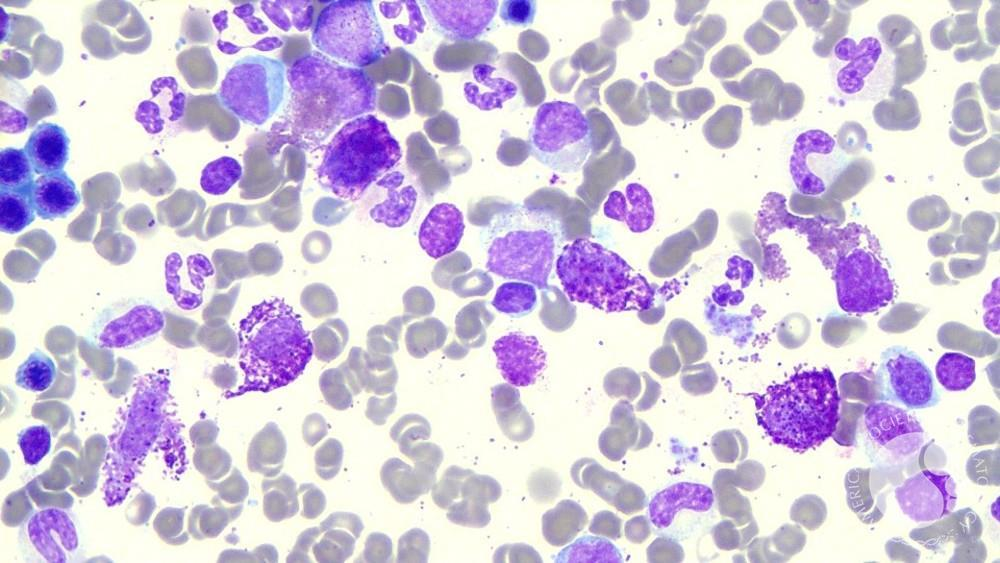

Essa rara doença do sangue tem muitas vezes o diagnóstico bastante desafiador e por vezes tardio. Vamos conhecê-la melhor.
Mastocitose – Desvendando os Mistérios de uma Doença Rara do Sistema Hematológico
No vasto mundo das condições médicas, há algumas que se escondem nas sombras da obscuridade, mesmo para os profissionais de saúde mais experientes. A mastocitose é uma dessas condições intrigantes, uma rara e pouco compreendida doença do sistema hematológico que merece nossa atenção. Nesta jornada pelo mundo da hematologia, mergulharemos um pouco na mastocitose, explorando suas origens, sintomas complexos e desafios de diagnóstico.
O enigma das Células Mastocitárias: Em nosso corpo, existem células silenciosas que possuem um papel de destaque em nossas respostas alérgicas e imunológicas. Essas células, chamadas de mastócitos, normalmente ficam à espreita nos tecidos, prontas para se mobilizarem quando uma ameaça se apresenta. Entretanto, em algumas circunstâncias, esses mastócitos começam se multiplicar de maneira descontrolada, ou seja, sem o devido estímulo para isso e desencadeiam uma série de eventos complexos que caracterizam a mastocitose.
O que é Mastocitose? A mastocitose é uma condição intrigante que resulta do crescimento excessivo de mastócitos. Essas células, que normalmente desempenham um papel crucial em nossa defesa imunológica, podem se tornar protagonistas de um enredo médico complexo quando sua proliferação se descontrola. As implicações dessa superprodução de mastócitos vão muito além das reações alérgicas tradicionais. Ela pode afetar a pele, órgãos internos e até mesmo levar a complicações mais graves, como leucemia de mastócitos.
Uma jornada rara e desafiadora: A raridade da mastocitose a torna um desafio não apenas para os pacientes que vivem com ela, mas também para os profissionais de saúde que buscam entender e tratar essa complexa condição. Com sintomas que podem imitar outras doenças e uma variabilidade impressionante na forma como se manifesta, a mastocitose frequentemente escapa da detecção precoce. No entanto, à medida que a pesquisa avança e novas abordagens diagnósticas emergem, estamos gradualmente lançando luz sobre essa enigmática condição.
Nos próximos segmentos deste artigo, vamos detalhar os tipos específicos de mastocitose, os sintomas que ela desencadeia, as formas de diagnóstico que estão sendo empregadas e as abordagens de tratamento que estão sendo exploradas. Junte-se a nós nessa jornada de descoberta, enquanto desvendamos os mistérios por trás da mastocitose e compartilhamos conhecimento valioso sobre essa fascinante doença do sistema hematológico.
Mastocitose Cutânea: Explorando suas Variedades e Manifestações
A mastocitose cutânea é o tipo mais comum de mastocitose e, como o próprio nome sugere, envolve a pele, daí muitos pacientes serem acompanhados e tratados pelo Dermatologista. Ela é frequentemente diagnosticada em crianças, embora possa afetar indivíduos de qualquer idade. Dentro da mastocitose cutânea, existem vários subtipos que variam em termos de gravidade e manifestações clínicas:
1. Urticária Pigmentosa: Este é o subtipo mais comum de mastocitose cutânea. Ele se manifesta como manchas avermelhadas ou amarronzadas na pele, frequentemente acompanhadas de coceira intensa. Quando a pele é friccionada, essas manchas podem inflamar temporariamente devido à liberação de histamina.

2. Telangiectasia Macularis Eruptiva Perstans (TMEP): Este subtipo apresenta lesões vermelhas e planas que podem se desenvolver em várias partes do corpo. Ao contrário da urticária pigmentosa, a coceira geralmente não é tão intensa.
3. Mastocitose Maculopapular Transitória da Infância (MMTI): Mais comum em crianças, a MMTI é caracterizada por lesões planas e elevadas que desaparecem com o tempo, muitas vezes durante a adolescência.
4. Mastocitoma Solitário: Neste subtipo, há uma única lesão na pele que pode parecer um nódulo ou protuberância. Embora a maioria seja benigna, é importante avaliar qualquer novo crescimento na pele.
Mastocitose Sistêmica: Enfrentando Desafios Mais Profundos
A mastocitose sistêmica, também conhecida como mastocitose disseminada, é uma forma mais grave da doença que envolve o crescimento anormal de mastócitos não apenas na pele, mas também em órgãos internos. Esta forma da doença é subdividida em categorias com base em sua gravidade e características específicas:
1. Mastocitose Sistêmica com Envolvimento de Órgãos (SM-AHNMD): Neste tipo, os mastócitos se acumulam em órgãos como fígado, baço, ossos e medula óssea. Isso pode causar sintomas mais generalizados e complicações associadas ao mau funcionamento dos órgãos afetados.
2. Leucemia de Mastócitos (LM): Esta é a forma mais grave da mastocitose, onde os mastócitos anormais se acumulam na medula óssea, levando a uma produção excessiva de células sanguíneas e comprometendo a função normal da medula.
Sintomas e Manifestações Clínicas da Mastocitose
A mastocitose é uma condição multifacetada, e os sintomas podem variar amplamente entre os pacientes, dependendo do tipo e da extensão da doença. Abaixo, vamos examinar as manifestações clínicas mais comuns associadas à mastocitose:
1. Sintomas Cutâneos: Muitas vezes, a mastocitose cutânea é a primeira a ser diagnosticada. Os sintomas cutâneos podem incluir:
- Urticária Pigmentosa: Manchas elevadas e coceira na pele que podem lembrar urticária.
- Prurido (coceira) Intensa: Coceira persistente e desconfortável, que pode ser desencadeada por estímulos como calor, fricção ou exercício.
- Rubor Facial: Vermelhidão súbita no rosto devido à liberação de histamina pelos mastócitos.
2. Sintomas Gastrointestinais: A mastocitose pode afetar o sistema gastrointestinal, levando a sintomas como:
- Diarreia: Frequentemente associada à liberação de mediadores inflamatórios pelos mastócitos.
- Dor Abdominal: Desconforto ou dor abdominal crônica, que pode ser intermitente.
- Náusea e Vômito: Pode ocorrer como resultado de reações mediadas pelos mastócitos.
3. Sintomas Sistêmicos: A mastocitose sistêmica, mais grave, pode causar sintomas mais generalizados, como:
- Fadiga e Fraqueza: Devido às respostas imunológicas e inflamatórias do corpo.
- Dificuldades Respiratórias: Em casos graves, podem ocorrer problemas respiratórios devido ao envolvimento dos pulmões.
- Hipotensão: Baixa pressão arterial repentina, resultado da liberação de mediadores vasodilatadores.
4. Anafilaxia: Uma complicação séria da mastocitose é a anafilaxia, uma reação alérgica grave que pode ser desencadeada por substâncias como alimentos, medicamentos, picadas de insetos e até mesmo estresse emocional. Essa reação ocorre quando os mastócitos liberam grandes quantidades de histamina e outros mediadores.
5. Envolvimento de Órgãos: Em alguns casos de mastocitose sistêmica, os mastócitos podem se acumular em órgãos como fígado, baço, medula óssea e ossos, causando complicações específicas para esses órgãos.
6. Reações a Estímulos: Uma característica única da mastocitose é a sensibilidade exacerbada a vários estímulos, como temperatura, pressão, exercício e emoções. Esses estímulos podem desencadear liberação de mediadores pelos mastócitos, levando a sintomas.
É fundamental que os pacientes estejam cientes desses sintomas e que os profissionais de saúde saibam identificá-los para um diagnóstico precoce e um manejo eficaz da doença. Lembre-se de ressaltar que a variabilidade nos sintomas pode tornar o diagnóstico desafiador, mas a pesquisa contínua está expandindo nosso entendimento e capacidade de abordar essa doença complexa.
Uma complicação séria da mastocitose é a anafilaxia, uma reação alérgica grave (…). Essa reação ocorre quando os mastócitos liberam grandes quantidades de histamina e outros mediadores.
Diagnóstico da Mastocitose: Desvendando a Complexidade
O diagnóstico preciso da mastocitose é fundamental para fornecer tratamento adequado e gerenciamento eficaz da doença. Dada a natureza complexa e variável dos sintomas, o diagnóstico da mastocitose muitas vezes envolve uma abordagem multifacetada. Duas abordagens cruciais para o diagnóstico incluem a biópsia de tecidos afetados e os avanços no diagnóstico molecular.
1. Biópsia de Tecidos: A biópsia é um procedimento fundamental para confirmar o diagnóstico de mastocitose. Ela envolve a retirada de uma amostra de tecido afetado para análise microscópica. Os locais mais comuns para a realização de biópsias incluem lesões cutâneas suspeitas e medula óssea.
- Biópsia da Pele: Em casos de mastocitose cutânea, a biópsia da pele ajuda a identificar a presença e a densidade de mastócitos anormais.
- Biópsia de Medula Óssea: Essa biópsia é crucial para a detecção de mastocitose sistêmica. A análise da medula óssea pode revelar a presença de mastócitos anormais e avaliar a extensão do envolvimento da doença.
2. Diagnóstico Molecular: Os avanços na tecnologia molecular têm proporcionado um entendimento mais profundo da mastocitose. A análise de mutações genéticas específicas associadas à mastocitose é uma ferramenta valiosa para confirmar o diagnóstico e determinar a gravidade da doença. Um dos principais genes associados à mastocitose é o KIT, que codifica uma proteína essencial para o desenvolvimento e a função dos mastócitos.
- Mutação D816V: A mutação D816V no gene KIT é frequentemente observada em pacientes com mastocitose. Sua detecção, muitas vezes através de testes moleculares, contribui para a confirmação diagnóstica.
3. Avanços no Diagnóstico Molecular: A pesquisa em mastocitose tem se concentrado em identificar marcadores genéticos e moleculares que possam melhorar a precisão do diagnóstico e fornecer informações prognósticas. Testes de mutação específicos, como a análise de mutações do gene KIT, estão se tornando mais acessíveis e podem ser realizados a partir de amostras de sangue.
Empoderando o Diagnóstico da Mastocitose: Em um cenário onde os sintomas variados podem confundir até os clínicos mais experientes, a combinação da biópsia de tecidos e dos avanços no diagnóstico molecular está revolucionando nossa capacidade de identificar a mastocitose. Essas abordagens não apenas confirmam a presença da doença, mas também ajudam a direcionar os tratamentos mais adequados e a fornecer uma visão mais clara da evolução da doença.
À medida que a pesquisa continua a expandir nosso entendimento da base genética da mastocitose, podemos antecipar diagnósticos mais precisos e uma abordagem mais personalizada para o tratamento. Juntos, a biópsia e o diagnóstico molecular estão desvendando os mistérios desta complexa condição hematológica, oferecendo esperança e otimismo para pacientes e profissionais de saúde.
Tratamento da Mastocitose: Gerenciando os Desafios
O tratamento da mastocitose é uma parte crucial da jornada dos pacientes, visando aliviar sintomas, melhorar a qualidade de vida e, quando possível, buscar a cura. Embora não haja uma abordagem única para todos os tipos e estágios da doença, diversas opções terapêuticas estão disponíveis para ajudar a controlar os sintomas e minimizar as complicações.
1. Manejo dos Sintomas: O tratamento da mastocitose muitas vezes começa com medidas para controlar os sintomas e minimizar o desconforto. Isso pode incluir:
- Anti-histamínicos: Medicamentos que bloqueiam os efeitos da histamina liberada pelos mastócitos, ajudando a controlar coceira, vermelhidão e outros sintomas alérgicos.
- Medicamentos Estabilizadores de Mastócitos: Esses medicamentos visam reduzir a liberação de mediadores inflamatórios pelos mastócitos, ajudando a prevenir episódios de anafilaxia e reduzir a intensidade dos sintomas.
2. Terapias Específicas: Para casos mais graves de mastocitose, terapias específicas podem ser necessárias:
- Inibidores de Tirosina Quinase: Medicamentos que alvejam as mutações no gene KIT, como a mutação D816V. Eles podem ajudar a reduzir a proliferação anormal dos mastócitos e controlar os sintomas sistêmicos. Um exemplo de droga que pode ser utilizada quando ocorre tal situação é o Midostaurin. O imatinibe, também usado no tratamento da Leucemia Mieloide Crônica, pode ser utilizado quando ocorre a mutação no gene KIT distinta a D816V ou outra variante no exon 17 KIT.
- Quimioterapia: Em casos de mastocitose avançada ou leucemia de mastócitos, a quimioterapia pode ser considerada.
3. Novas Opções Terapêuticas: A pesquisa contínua na área de mastocitose está gerando esperança com o desenvolvimento de novas opções terapêuticas:
- Inibidores de Mutação KIT: Terapias direcionadas estão sendo exploradas para inibir mutações específicas no gene KIT, abrindo novas perspectivas para o tratamento.
- Imunoterapia: Pesquisas estão investigando como a imunoterapia pode ser usada para modular a resposta imunológica e reduzir a atividade dos mastócitos.
4. Possibilidade de Cura: A mastocitose, especialmente em suas formas mais graves, pode representar um desafio formidável. Embora a cura completa possa ser difícil de alcançar, os avanços no diagnóstico e no tratamento estão melhorando as perspectivas dos pacientes. A terapia direcionada e as abordagens personalizadas estão aumentando as chances de controle da doença, remissão e uma melhor qualidade de vida.
Mastocitose: Rumo a um Futuro Promissor com a Evolução da Ciência
Enquanto embarcamos na conclusão desta jornada pela mastocitose, é inspirador reconhecer o tremendo progresso que a ciência médica tem feito na compreensão e no tratamento desta complexa condição hematológica. O futuro da mastocitose é iluminado por avanços científicos e inovações médicas que estão redefinindo a maneira como abordamos essa doença rara.
Avanços Promissores na Pesquisa: Os últimos anos testemunharam um crescimento exponencial no conhecimento sobre a mastocitose. Pesquisadores estão se dedicando a desvendar os mistérios genéticos por trás da doença, identificando novos alvos terapêuticos e desenvolvendo tratamentos direcionados. Esses avanços estão permitindo uma abordagem mais precisa e personalizada para o tratamento da mastocitose.
Terapias Personalizadas: A evolução da ciência está conduzindo a uma nova era de terapias personalizadas, onde os pacientes podem se beneficiar de tratamentos adaptados às suas necessidades específicas. À medida que compreendemos melhor as variações genéticas subjacentes à mastocitose, podemos desenvolver abordagens terapêuticas direcionadas que atuam de maneira mais eficaz e com menos efeitos colaterais.
Colaboração Internacional: A pesquisa em mastocitose é verdadeiramente global, com cientistas, médicos e pacientes se unindo em todo o mundo para compartilhar conhecimento e impulsionar a inovação. A colaboração internacional está acelerando nossa compreensão da doença, acelerando o desenvolvimento de novos tratamentos e trazendo novas perspectivas à luz. É uma realidade também que estudos clínicos estão em andamento e muitos pacientes e médicos são encorajados a buscar centros de pesquisa clínica em que esses estudos ocorrem a fim de oferecer novas opções que estão em desenvolvimento.
Esperança para um Futuro Melhor: Com esses avanços emocionantes, o futuro da mastocitose parece mais promissor do que nunca. A jornada para o tratamento ideal e, possivelmente, para a cura está em andamento. À medida que a ciência evolui, os pacientes podem vislumbrar uma realidade onde os sintomas são mais controlados, as complicações são minimizadas e a qualidade de vida é melhorada significativamente.
Conclusão: Além do Horizonte: À medida que concluímos nossa exploração da mastocitose, é vital lembrar que por trás dos desafios e complexidades existe uma comunidade resiliente e esperançosa. A mastocitose não é apenas um conjunto de sintomas e tratamentos; é uma história de superação, inovação e progresso. À medida que continuamos a trilhar esse caminho, sabemos que o futuro será moldado por nossa capacidade de abraçar a evolução da ciência, colaborar com paixão e enfrentar o desconhecido com coragem. A mastocitose, assim como seus pacientes e defensores, está rumando em direção a um horizonte cheio de possibilidades brilhantes e transformadoras. A mastocitose, independentemente do tipo, apresenta um quadro clínico diversificado e desafiador. Com a mastocitose cutânea, os sintomas são mais localizados na pele, enquanto a mastocitose sistêmica pode afetar órgãos internos e causar sintomas mais generalizados. A variação na gravidade e nas manifestações clínicas torna o diagnóstico e o tratamento um processo complexo, mas os avanços na pesquisa estão iluminando o caminho para abordagens mais eficazes e personalizadas para cada tipo de mastocitose.
#mastocitose #mastocitosesistemica #mastocitos
#hematologia #neoplasia #leucemia #hematonaweb
